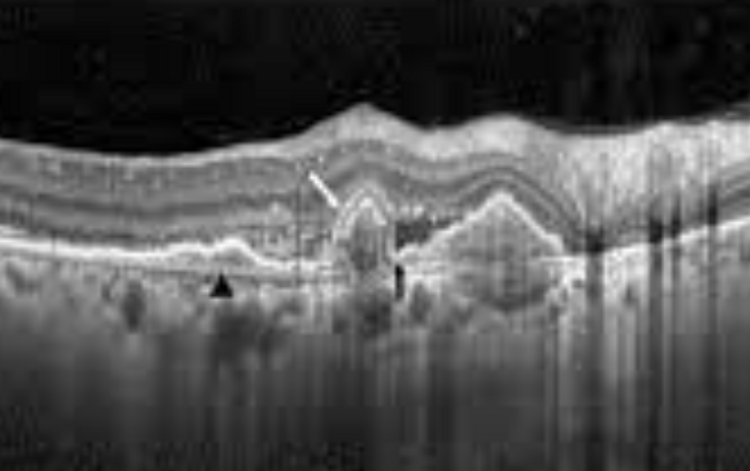

Introduction
The choriocapillaris neovascularisation pushes into the subretinal space, developing bulbs or polypoids, which are effectively aneurysmal lesions.
- More common in Asian populations. (60% of NV aged-related vision loss)
- Caucasian PCV reported to cause 13% of age related NV loss
Dead Giveaways
The most obvious feature is the presence of the steeply peaked PEDs, indicating the area of polypoidal lesions
There is usually an associated area of FIPED:

Large PED with right side FIPED The FIPED typically indicates an area of Type 1 neovascularisation, which leads to the polypoidal lesions
Note the PED is mixed hyper and hypo-reflective, due to vascular internal content
Also note how the PED has a double peak. This is a notched PED, and is typical of PCV
Also note the RPE, Bruch's membrane and outer retinal disturbances
Angiography
OCT-A will visualise the neovascular membranes, and will appear almost identical to PNV
As a result, indocyanine green angiography (ICG-A) is used

Stratfield Retinal Clinic took a really nice picture of the polypoidal aneurysm bulbs
Fundus Image:

Note haemorrhaging all over, as well as orange-red deposits The orange-red deposits in the bottom left can be associated with exudates or haemorrhages, with a lot of exudative material surrounding lesions.
Haemorrhages can also occur. On red-free, would have alternating areas of hyper and hypo autofluorescence
diagnostic features
PCV is almost always associated with:
Exudation
Haemorrhaging (subretinal or sub-RPE)
Both
Risk Factorss
Smoking